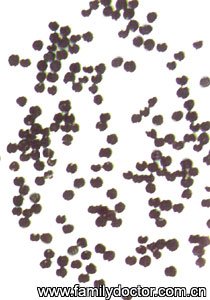
������SemenCelosiae/������ Semen Celosiae

青葙子 Semen Celosiae
http://www.100md.com
家庭医生医疗保健网
![]() |
| 青葙子 Semen Celosiae |
![]() |
| 青葙子 Semen Celosiae |
青葙子
(英) Feather Cockscomb Seed
[别名] 野鸡冠花、狼尾花、大尾鸡冠花。
[来源] 为苋科植物青葙Celosia argentea L.的种子。
[植物形态] 一年生草本,高达1m。茎直立,绿色或带红紫色,有纵条纹。叶互生,披针形或椭圆状披针形,长5—9cm,宽1—3cm。穗状花序顶生或腋生;苞片、小苞片和花被片干膜质,淡红色,后变白色,苞片3;花被片5;雄蕊5,花丝下部合生成杯状;子房上位,柱头2裂。胞果卵形,盖裂。种子扁圆形,黑色,有光泽。花期5—7月,果期8—9月。
生于平原或山坡;有栽培,几乎遍布全国。
[采制] 秋季果实成熟时采割植物或摘取果穗,晒干,收集种子。
[性状] 种子扁圆形,少数圆肾形,直径1—1.5mm。表面黑色或红黑色,光亮,中间微隆起,侧边微凹处有种脐。种皮薄而脆。无臭,无味。
[化学成份] 含脂肪油、淀粉、烟酸、硝酸钾。
[性味] 性微寒,味苦。
[功能主治] 清肝,明目,退翳。用于肝热目赤、眼生翳膜、视物昏花、肝火眩晕。用量4.5—9g。, http://www.100md.com